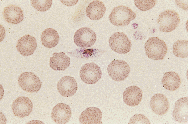

Although endemic malaria was eradicated from Australia by 1981, the vectors remain and transmission from imported cases still occurs. Climate modelling shows that global warming will enlarge the potential range of the main vector, Anopheles farauti sensu stricto; by the year 2030 it could extend along the Queensland coast to Gladstone, 800 km south of its present limit. Vigilance and a dispassionate assessment of risk are needed to meet this challenge.
Although endemic malaria was eradicated from Australia by 1981, the vectors remain and transmission from imported cases still occurs. Climate modelling shows that global warming will enlarge the potential range of the main vector, Anopheles farauti sensu stricto; by the year 2030 it could extend along the Queensland coast to Gladstone, 800 km south of its present limit. Vigilance and a dispassionate assessment of risk are needed to meet this challenge.
Introduction
Australia has long been under threat from malaria and this has led many to predict, from early times, that without vigilance there will be outbreaks.1 Climate change due to the enhanced greenhouse effect is expected to extend vector ranges2and potentially expand the threat. It is timely to review the epidemiology of malaria in Australia and explore its future with climate change.
Although malaria transmission has occurred widely in Australia,3 the disease was eradicated by 1981.4 Imported cases (acquired outside Australia) and introduced cases (derived from imported cases), which still occur, do not invalidate this "free from endemic malaria" status; malaria is considered endemic only if parasitaemia arises from introduced cases or other endemic infections.5 However, Australia remains vulnerable to malaria transmission, as the vectors have not been eradicated and hundreds of cases are imported annually.
Natural infections have been found in Anopheles hilli and An. farauti6sensu lato (s.l.) (a group of three morphologically indistinguishable species,7,8 found in northern Australia,6 which have not yet been given formal names). In southern Australia, An. annulipes s.l. is the putative vector.3An. amictus, An. bancroftii and An. stigmaticus are susceptible to malaria in the laboratory6 and may play a role in the field. Nevertheless, experience since the 1900s strongly supports the hypothesis that An. farauti s.l. is the most important vector.
 Receptivity to malaria
Receptivity to malaria
Ford9 delineated the potentially malarious area of Australia, within which "implantation" may occur, as extending south to latitude 19oS in Queensland, to about 17oS in the Northern Territory and to about 19oS in Western Australia, except for a non-receptive coastal strip including Broome at 18oS. Although transmission had occurred widely outside this area, Ford thought conditions elsewhere did not favour maintenance of transmission. The area north of 19oS, largely coinciding with the range of An. farauti s.l.,6 is now regarded as receptive.3
Australia's receptivity was tested with the return of large numbers of infected servicemen after the world wars: few malaria infections were transmitted outside the receptive zone.3 Even within the receptive zone, local transmission is rare despite imported cases. Possible reasons include:
Australia's receptivity was tested with the return of large numbers of infected servicemen after the world wars: few malaria infections were transmitted outside the receptive zone.3 Even within the receptive zone, local transmission is rare despite imported cases. Possible reasons include:
- Australian mosquitoes may not be susceptible to imported malaria parasites. Not all vectors and malaria strains are compatible; the European vector, An. atroparvus, cannot be infected with an African strain of Plasmodium falciparum.10 The susceptibility of Australian mosquitoes to parasites from different geographic regions is largely unknown.
- Many cases of falciparum malaria do not produce gametocytes to infect vectors, as over half the notified cases are diagnosed (and presumably treated) within three days of onset of symptoms; 11P. falciparum gametocytes mature about 10 days after the appearance of asexual parasites.5 Only 25% of P. falciparum-infected patients from 1989 to 1995 in New South Wales were gametocytaemic at diagnosis (Dr J Walker, Centre for Infectious Diseases and Microbiology, Westmead Hospital, NSW, personal communication).
- Mosquito-to-human density is low. Anopheles mosquitoes usually have a restricted flight range of 1-2 km. The most prolific larval habitats are permanent or semipermanent natural pools, which are uncommon in urban areas.
- A low proportion of blood meals are taken from humans. Anopheles mosquitoes feed at night and in Australia are both reluctant to enter houses and restricted by the widespread use of screens (some introduced cases have occurred in soldiers in camps and prospectors who were not so protected3). Feeding on humans is reduced further by the use of repellents and the presence of alternative hosts; An. farauti s.l. in Darwin fed preferentially from dogs rather than humans.12
- Vector longevity is short. In Darwin only 3%-4.3% of An. farauti s.l. mosquitoes, 0.1%-2.6% of An. bancroftii and 0.3% of An. hilli lived long enough to allow sporozoite development.13
The future
The worsening malaria situation in some neighbouring countries and increasing travel between them and Australia led the incidence of imported malaria to nearly double in Australia between 1981 and 1991.11 Combined with the possibility of expanded vector distribution due to climate change, this has led to calls for reassessment of Australia's receptiveness to malaria.14
Climate change is expected to lead to:
- More frequent cyclones and floods, which will increase vector density and the risk of malaria. Past epidemics were often associated with above-average rainfall.3
- Inundation of low-lying areas, due to raised sea levels. Within the Asia-Pacific Region, many such areas are malarious and refugees from them could provide a large reservoir of infection. Emergency relocation of refugees, particularly if aircraft are used, will increase the possibility of introducing exotic vectors into Australia. Drug-resistant malaria parasites will add to the difficulties of treatment.
Changes in vector distribution
As An. farauti sensu stricto (s.s.) (or No. 1 of the three species belonging to An. farauti sensu lato)15 is an important vector,16 we investigated its present and future distribution with the CLIMEX climate-matching model17 and the method of Hutchinson to infer meteorological data.18 An annual ecoclimatic index was derived for each location to describe its climatic suitability for the persistence and growth of the mosquito population on a scale of 0-100. Parameter values for climate matching were derived from field studies of the distribution and phenology of An. farauti s.s. and temperature-controlled experiments with the mosquito.16,19,20
The potential distribution of An. farauti s.s. was estimated under a recent climate-change scenario for the year 2030, with increases of 1.5oC in temperature and 10% in summer rainfall in northern Australia21(Figure 3).
The present modelled distribution of An. farauti s.s. is largely coastal, which agrees with its known distribution on the Cape York Peninsula and in the Northern Territory. An. farauti s.l. occurs rarely in northern Western Australia (it has been recorded only twice, at Kununurra16), but this was not predicted, probably because it requires exceptionally rainy years or irrigation to survive.
Under the climate-change scenario for the year 2030, the potential distribution of An. farauti s.s. extends a further 800 km south in coastal Queensland, to Gladstone (23o50'S). This would encompass the Whitsunday Passage with its tourist population. However, the ecoclimatic indices from Townsville south are low, indicating a limited vector density and hence a low receptivity for malaria.
Conclusions
Malaria has long been a threat in Australia, but recently the threat has been sensationalised.14 It is timely to recall Mapleton's advice, given in 1922 in the MJA,22to cease making "tropical Australia appear a hot-bed of dread diseases". In the last 70 years, our understanding of malaria and our ability to control it have increased. Our study indicates that conditions under climate change will become more suitable for the primary vector. To meet this challenge we require vigilance, an understanding of malaria epidemiology and a dispassionate assessment of the risks.
References
- Evans W. Antimalarial work in the Australian Mounted Division, Palestine. Its relation to the same problem in Australia. Med J Aust 1919; 2: 526-529.
- Sutherst RW. Arthropods as disease vectors in a changing environment. In: Lake JV, Bock GR, Ackrill K, editors. Environmental change and human health. Chichester: John Wiley and Sons, 1993: 124-145.
- Black RH. Malaria in Australia. Sydney: University of Sydney, 1972.
- World Health Organization. Synopsis of the world malaria situation in 1981. Wkly Epidemiol Rec 1983; 58: 197-199.
- Bruce-Chwatt LJ. Essential malariology. London: William Heinemann Medical Books Ltd, 1980: 23.
- Mackerras IM. The Australasian anophelines as vectors of malaria. Med J Aust 1947; 1: 1-8.
- Bryan JH. Studies on the Anopheles punctulatus complex. 1. Identification by proboscis morphological criteria and by cross-mating experiments. Trans R Soc Trop Med Hyg 1973; 67: 64-69.
- Mahon RJ, Miethke PM. Anopheles farauti No. 3, a hitherto unrecognized biological species of mosquito within the taxon A. farauti Laveran (Diptera: Culicidae). Trans R Soc Trop Med Hyg 1982; 76: 8-12.
- Ford E. The malaria problem in Australia and the Australian Pacific Territories. Med J Aust 1950; 23: 749-760.
- Shute PG. Failure to infect English specimens of Anopheles maculipennis var. atroparvus with certain strains of Plasmodium falciparum of tropical origin. J Trop Med Hyg 1940; 43: 175-178.
- Sleigh A, Srinivasa M, Cooper A, et al. Report of the Australian malaria register for 1991. Brisbane: Tropical Health Program, 1992: 4; 1.
- Foley DH, Whelan P, Bryan JH. A study of two sibling species of Anopheles farauti Laveran sensu lato (Diptera: Culicidae) at Darwin, Northern Territory. J Aust Entomol Soc 1991; 30: 269-277.
- Russell RC. Seasonal abundance, longevity and population age composition of potential malaria vectors in northern and southern Australia. Aust J Zool 1987; 35: 289-306.
- Murray-Smith S, Weinstein P. A time bomb in north Queensland: a case report of introduced malaria south of the nineteenth parallel. Comm Dis Intell 1993; 17: 211-213.
- Foley DH, Meek SR, Bryan JH. The Anopheles punctulatus group of mosquitoes in the Solomon Islands and Vanuatu surveyed by allozyme electrophoresis. Med Vet Entomol 1994; 8: 340-350.
- Lee DJ, Hicks MM, Griffiths M, et al. The Culicidae of the Australasian region, Vol. 5. Canberra: AGPS, 1987: 186-195.
- Sutherst RW, Maywald GF, Skarratt DB. Predicting insect distributions in a changed climate. In: Harrington R, Stork NE, editors. Insects in a changing environment. London: Academic Press, 1995: 59-91.
- Hutchinson MF. A new objective method for spatial interpolation of meteorological data from irregular networks applied to the estimation of monthly mean solar radiation, temperature, precipitation and wind run. CSIRO Div Water Res Tech Memo 1989; 5: 95-104.
- Sweeney AW, Cooper RD, Frances SP. Distribution of the sibling species of Anopheles farauti in the Cape York Peninsula, Northern Queensland, Australia. J Am Mosq Control Assoc 1990; 6: 425-429.
- Cooper RD, Frances SP, Sweeney AW. Distribution of members of the Anopheles farauti complex in the Northern Territory of Australia. J Am Mosq Control Assoc 1995; 11: 66-71.
- CSIRO Division of Atmospheric Research. Climate change scenarios for the Australian region. Melbourne: 1992: 1-6.
- Maplestone PA. Research in tropical Australia [letter]. Med J Aust 1922; 1: 476-477.
Author details
University of Queensland, Brisbane, QLD.
- Joan H Bryan
- Desmond H Foley
- Robert W Sutherst




